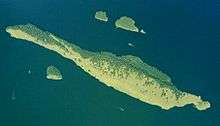

Spieden Island
Spieden Island is a privately owned island (James Jannard—founder and major shareholder of Oakley, Inc.[1]) in the San Juan Archipelago in the U.S. state of Washington. It has a land area of 516.4 acres (209.0 ha) and no permanent resident population as of the 2000 census.
Geography
Two miles long, half a mile across at its widest point, and 374 feet above sea level at its highest point, it is less than a mile north of San Juan Island, across the Spieden Channel. The unusual climate makes the north side heavily forested and the south side barren. Large boulders, called "glacial erratics," are scattered around the south side, left there when the glaciers receded millennia ago.
History
Spieden Island was named by Charles Wilkes during the Wilkes Expedition of 1838-1842, to honor William Speiden, the purser of the expedition's Peacock.[2]
In the 1970s the island was used for big game hunting; game animals were imported and a hotel, airport, and small hangar built to accommodate visitors. This no longer occurs due to the risk of shots carrying across to highly populated San Juan Island.
The Island Institute, an environmental education camp run by Jane Howard, was located on the island. It is no longer in operation.[3]
The resident animal population still includes exotic animals such as Mouflon sheep from Corsica, fallow deer from Europe, and Sika deer from Asia.[4]
Notes
- ↑ http://www.bizjournals.com/seattle/stories/1997/02/17/tidbits.html
- ↑ Phillips, James W. (1971). Washington State Place Names. University of Washington Press. ISBN 0-295-95158-3.
- ↑ "True rumors about Spieden Island". King5.com. 2 August 2005. Archived from the original on November 5, 2008. Retrieved 28 February 2009.
- ↑ KING5 Seattle News – True rumors about Spieden Island. KING5.com. Accessed August 9th, 2006.
- Spieden Island: Blocks 4001 and 4002, Census Tract 9603, San Juan County, Washington United States Census Bureau
Coordinates: 48°38′29″N 123°08′11″W / 48.6413°N 123.1365°W